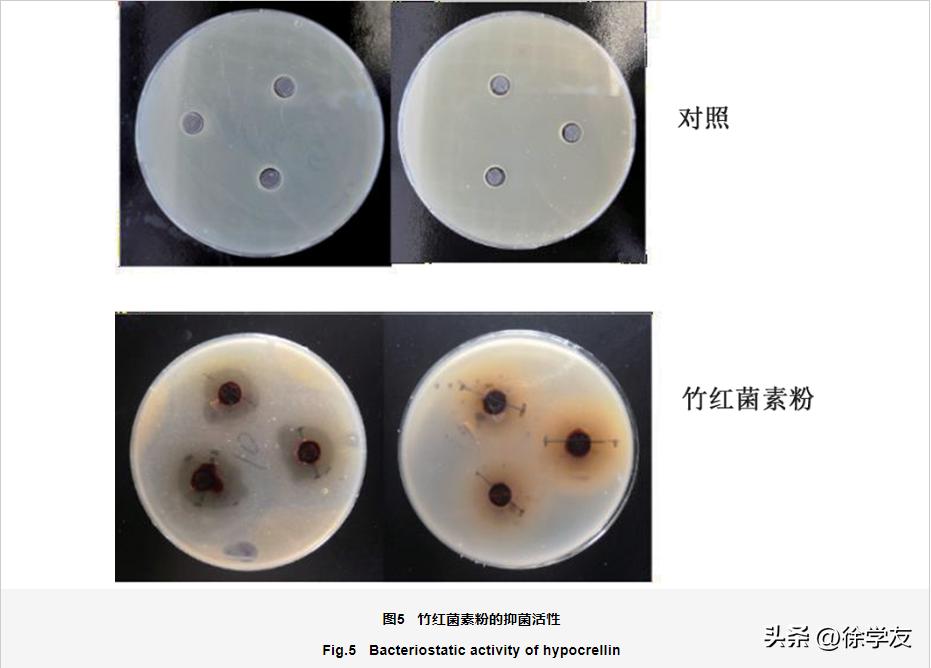
竹红菌素中试提纯工艺及抑菌活性研究

全文链接:http://www.sdkx.net/CN/10.3976/j.issn.1002-4026.2023.02.002
引用格式:孙博通, 李洪亮, 韩如冰, 等. 竹红菌素中试提纯工艺及抑菌活性研究[J]. 山东科学, 2023, 36(2): 8-15 doi:10.3976/j.issn.1002-4026.2023.02.002.

摘要
为了研究竹红菌素的中试提纯工艺及抑菌效果,在中试生产中,通过不同溶剂、提取方法提取竹红菌素,研究盐析法、降温法和超滤法对竹红菌素的纯化效果。结果表明使用气流粉碎法竹红菌素提取量可达21.4 mg/g,超滤法纯化后,竹红菌素的纯度达到90%以上。对竹红菌素的抑菌活性分析发现,其热稳定性良好,并且对大肠埃希氏菌和白色念珠菌均有抑制作用。竹红菌素具有天然抗菌和良好的热稳定性,易提取纯化,可作为一种抑菌药物应用到医药等领域。
关键词: 竹红菌素; 提取; 纯化; 稳定性; 抑菌
Abstract
To study the pilot-scale purification process and bacteriostatic effect of hypocrellin during the pilot-scale production, we extracted hypocrellin using different solvents and extraction methods. Then, we investigated the purification effects of the hypocrellin using salting-out, physical cooling, and ultrafiltration methods. The results showed that the amount of hypocrellin extracted using the jet pulverization method could reach up to 21.4 mg/g, and its density could exceed 90% after its purification via ultrafiltration. The analysis of the bacteriostatic activity of hypocrellin showed that it had good thermal stability and inhibitory effects against Escherichia coli and Candida albicans . We found that hypocrellin has natural antibacterial properties and good thermal stability, is easy to extract and purify, and can be used as a bacteriostatic drug in medicine and other applications.
Keywords: hypocrellin; extraction; purification; stability; bacteriostatic activity